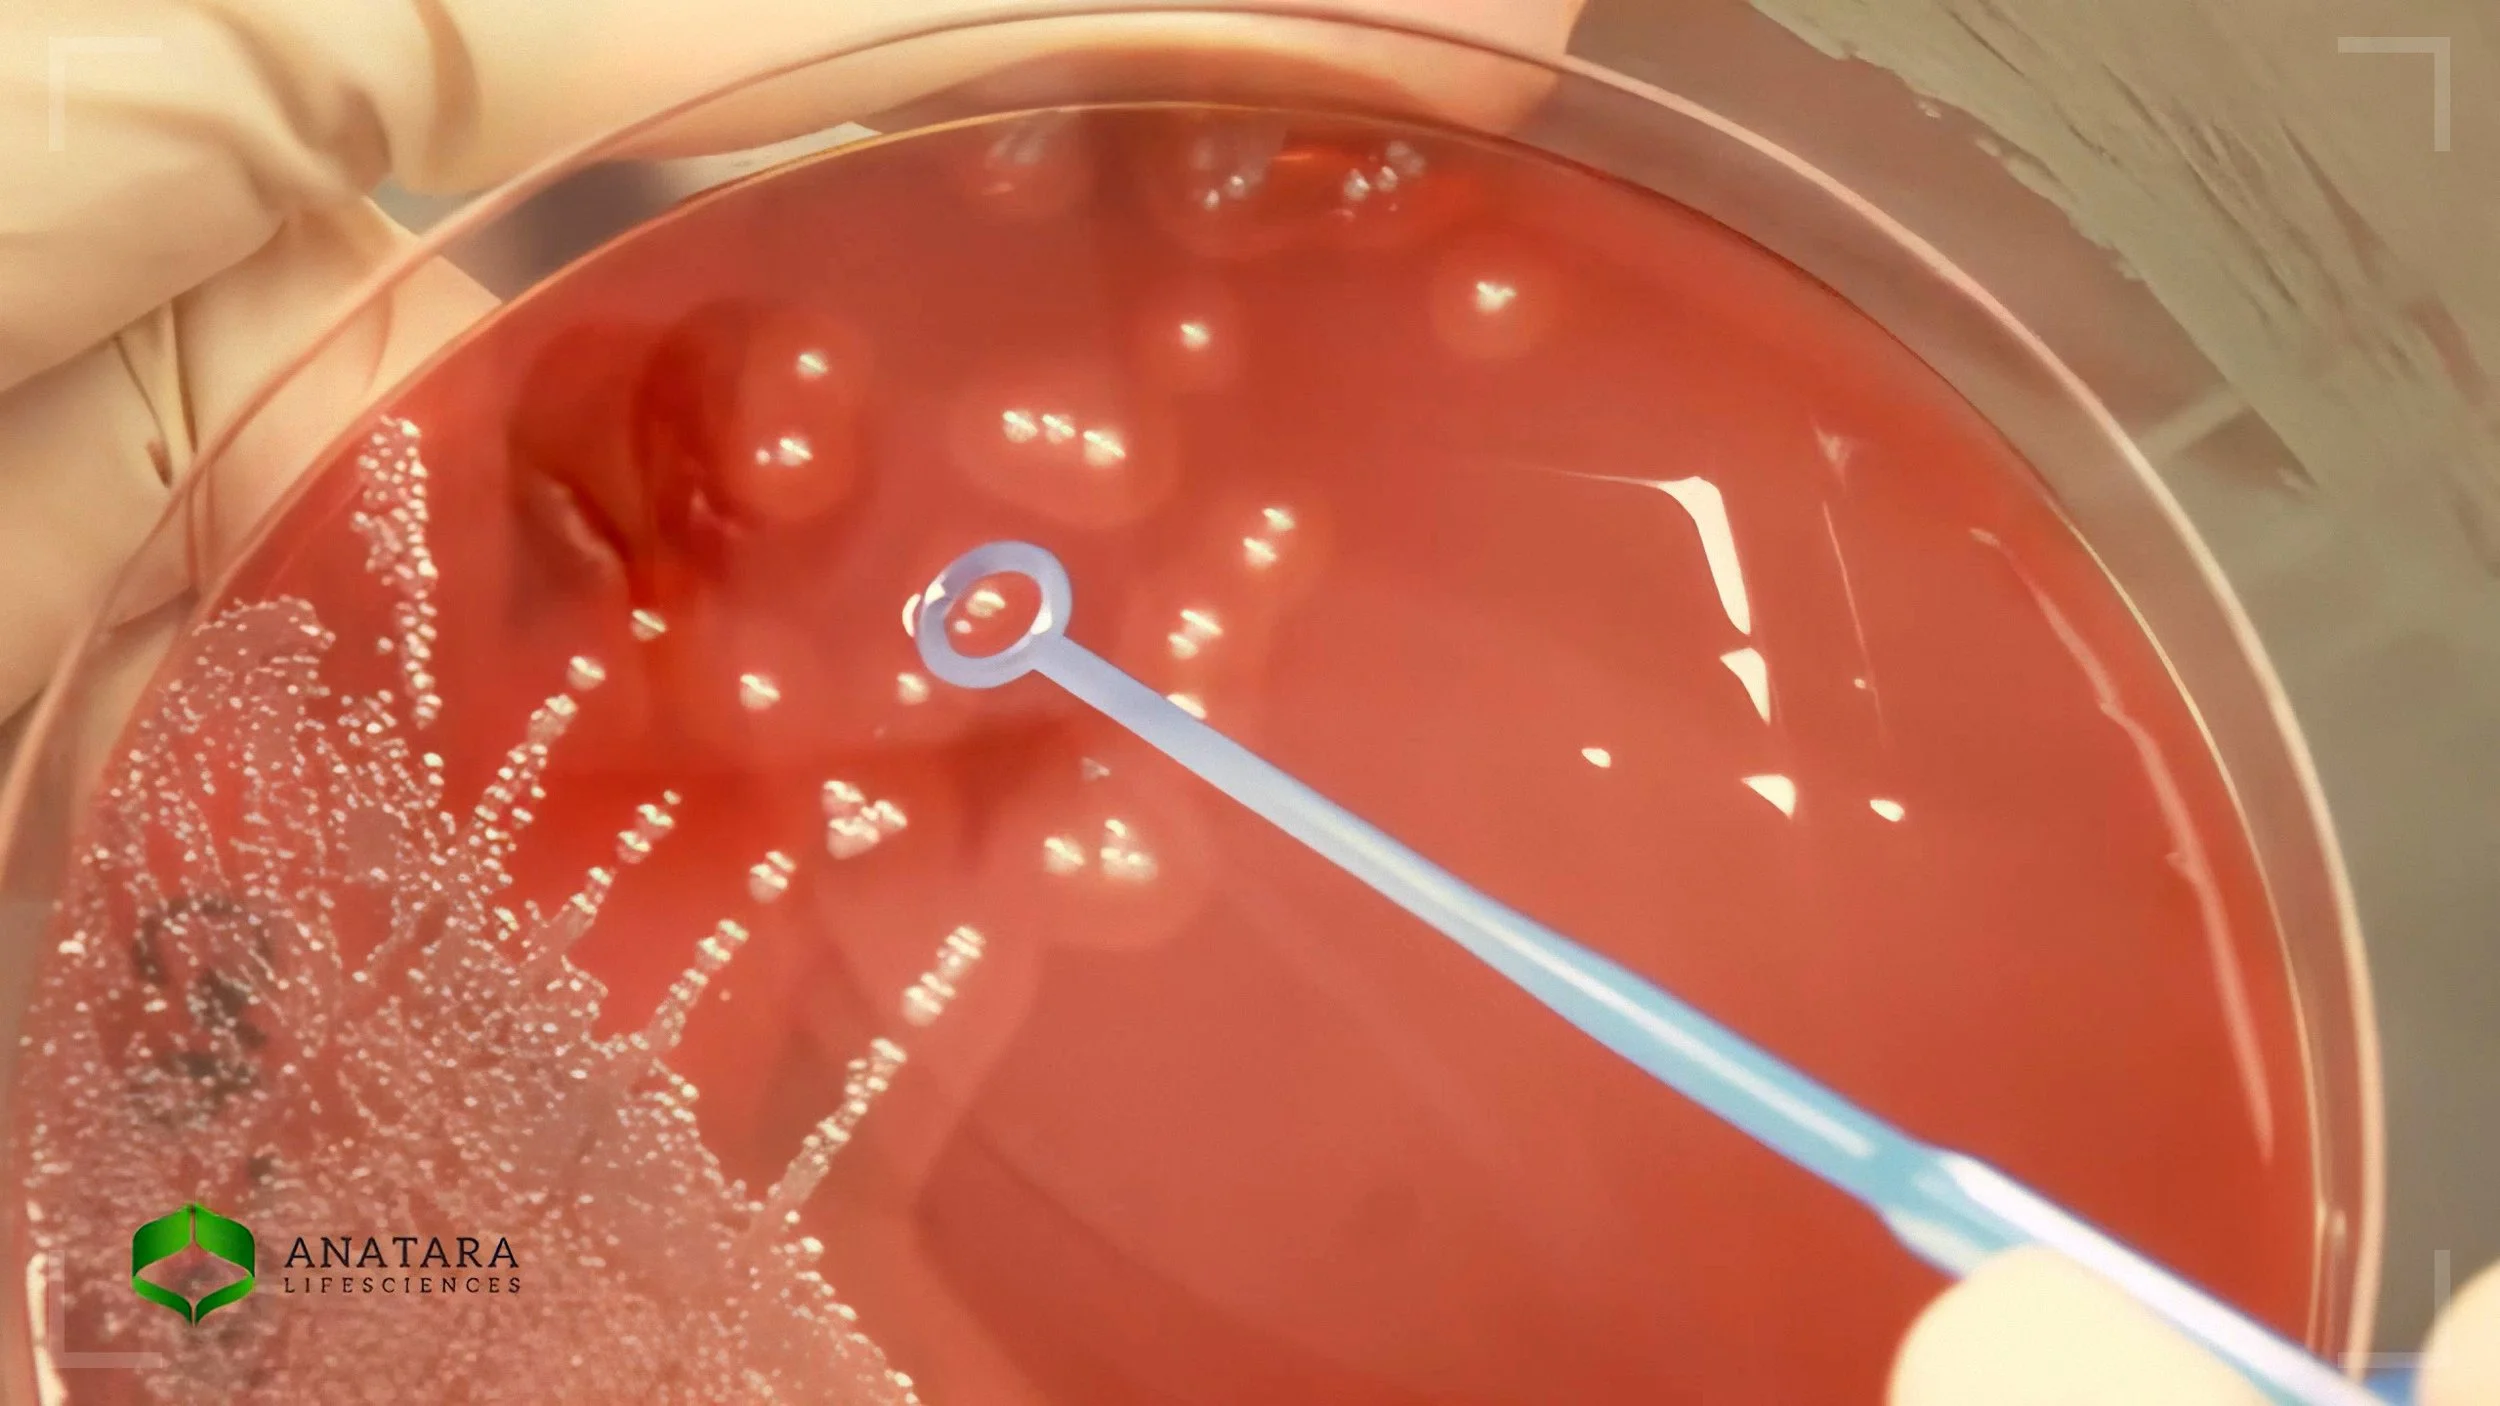
Anatara.Lifesciences_09.jpg

Anatara Lifesciences
Early Stage Investment equity raising film. Anatara Lifesciences successfully listed on the ASX.

Early Stage Investment equity raising film. Anatara Lifesciences successfully listed on the ASX.